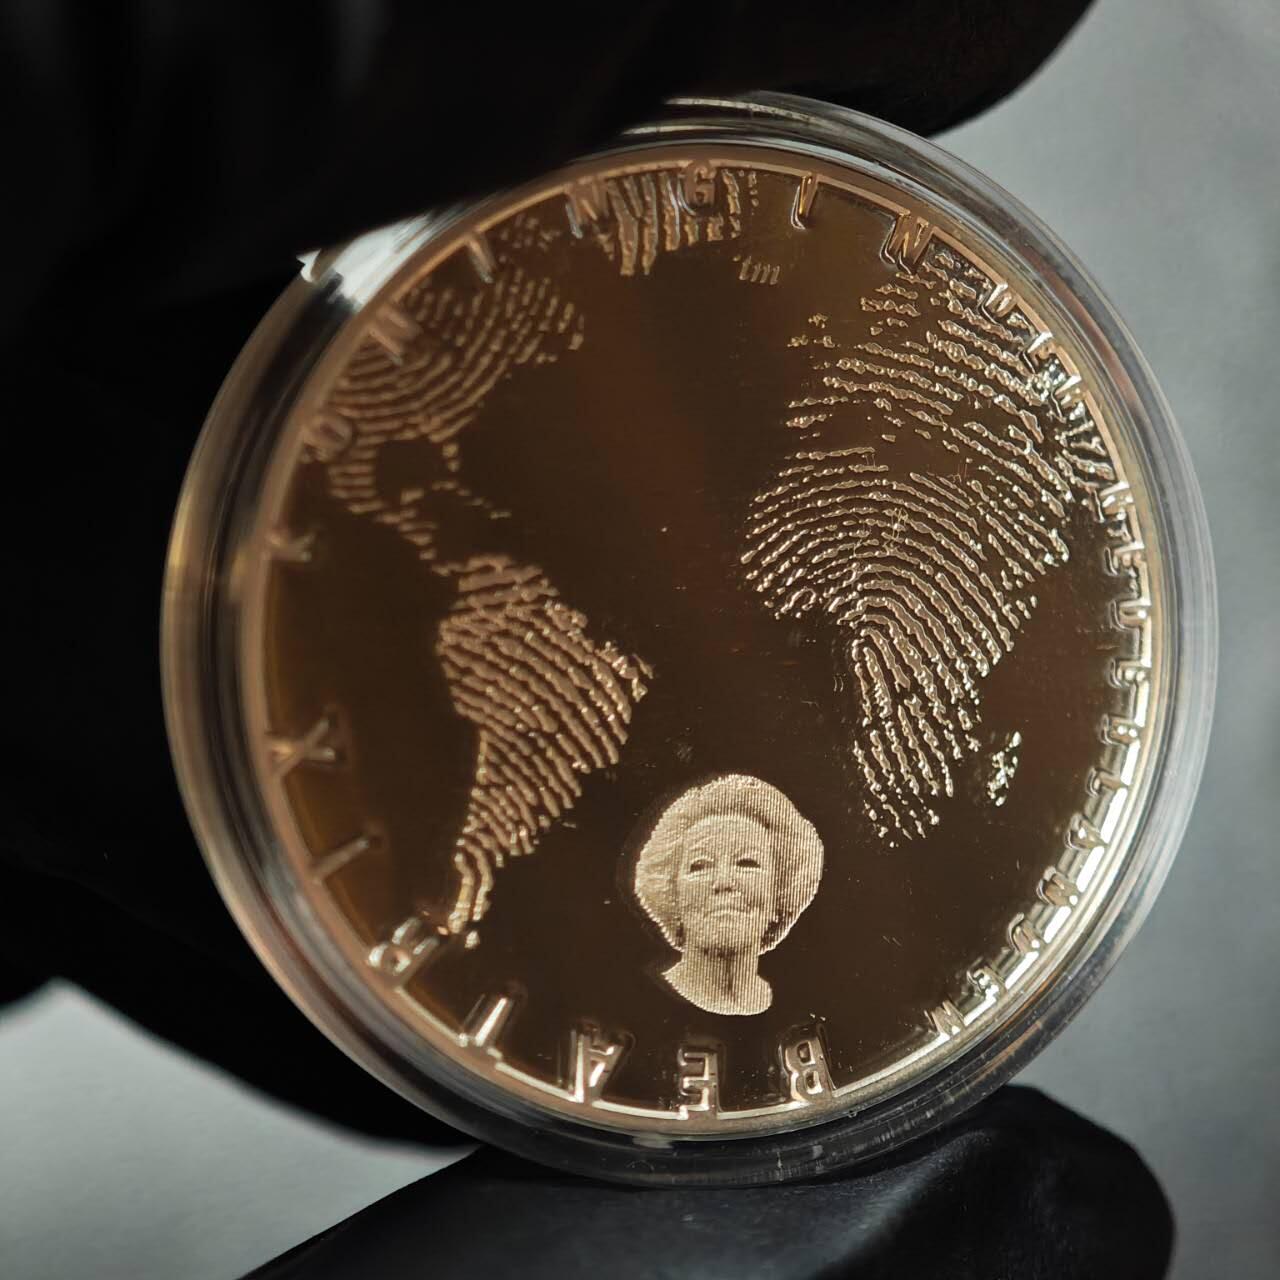
金瓯小拍第三期 古今币章 银价专场 荷兰精制银币2012年 重15.5克 阿姆斯特丹运河世界文化遗产主题

-
Lot.1
法国农业部大银章1896年 重64克直径50mm 边铭丰饶角ARGENT 带原盒无法关闭
起价:0元 当前价:0元 -
Lot.2
法国库尔贝瓦市城市服务镀金银章1940年 重62克直径50.2mm 边铭丰饶角2ARGENT
起价:0元 当前价:0元 -
Lot.3
英国布拉德菲尔德大学银章 重25.8克直径38.7mm 浓郁包浆黑中透金
起价:0元 当前价:0元 -
Lot.4
英国南部马拉松冠军镀金银章1957年 重19.1克直径31.8mm 极佳好品带五彩环彩
起价:0元 当前价:0元 -
Lot.5
法国雷莫斯保险公司银章1879年 重18.3克直径33.7mm 边铭ARGENT 好品带原光
起价:0元 当前价:0元 -
Lot.6
中国台湾省蒋公九秩银章 重17.4克直径33mm
起价:0元 当前价:0元 -
Lot.7
加拿大枫叶银币2008年 重31.3克直径38mm 品相一般 磨砂处理+划痕
起价:0元 当前价:0元 -
Lot.8
奥地利爱乐银币2013年 重31.1克直径37mm 品相一般 通体白雾
起价:0元 当前价:0元 -
Lot.9
法国巴黎大银章1964年 重61.2克直径49.8mm 边铭丰饶角1ARGENT
起价:0元 当前价:0元 -
Lot.10
法国复刻埃居大银章 重33克直径49mm 边铭丰饶角1 限量500枚
起价:0元 当前价:0元 -
Lot.11
英国大都会中学银章1914年 重20.2克直径32mm 镜面带刻字
起价:0元 当前价:0元 -
Lot.12
法国城市人寿保险公司银章 重20.8克直径36.3mm 边铭丰饶角ARGENT
起价:0元 当前价:0元 -
Lot.13
法国萨尔特省农业协会银章 重20.2克直径36.8mm 边铭丰饶角ARGENT100
起价:0元 当前价:0元 -
Lot.14
奥地利特蕾莎大奶妈银币 后铸 重28.0克直径40.4mm
起价:0元 当前价:0元 -
Lot.15
澳大利亚镶金熊猫笑翠鸟银币1997年 重0.5克金31.1克银直径 证书编号02022 背面有一处硫化斑
起价:0元 当前价:160元 -
Lot.16
澳大利亚镶金熊猫笑翠鸟银币1995年 重0.5克金31.1克银直径 证书编号2659 蓝色盒装
起价:0元 当前价:160元 -
Lot.17
英国5便士1对2枚精制银币1990年 重3.25克+5.65克 状态极佳无氧化硫化 盒证齐全
起价:0元 当前价:0元 -
Lot.18
英国50便士1对2枚精制银币1997年 重8克+13.5克 小版有氧化 盒证齐全
起价:0元 当前价:0元 -
Lot.19
英国不列颠女神投资银币2023年 重31.1克 查尔斯国王头像 有淡白斑
起价:0元 当前价:0元 -
Lot.20
英国女王神兽黑牛银币2018年 重62.3克 一面有大量同向清理发丝痕
起价:0元 当前价:0元 -
Lot.21
英属直布罗陀海军主题澳大利亚黑水鸡驱逐舰银币1993年 重28.5克 轻微氧化
起价:0元 当前价:0元 -
Lot.22
英属马恩岛英勇十字勋章银币2004年 重28.3克 状态较好
起价:0元 当前价:0元 -
Lot.23
圣马力诺最后的里拉精制银币2001年 重18克直径32mm 状态较好
起价:0元 当前价:0元 -
Lot.24
波兰罗兹犹太区设立65周年银币2009年 重28.28克直径38.6mm 做旧仿古工艺
起价:0元 当前价:0元 -
Lot.25
芬兰北欧世界滑雪锦标赛银币1989年 重24.1克直径35mm
起价:0元 当前价:0元 -
Lot.26
法国勃兰登堡门精制银币1993年 重22.2克直径37mm 法郎+ECU双面额
起价:0元 当前价:0元 -
Lot.27
法国文艺复兴主题精制银币2000年 重22.2克直径37mm 状态较好
起价:0元 当前价:0元 -
Lot.28
苏联1980年莫斯科奥运会赛马半盎司纯银纪念银币 16.57克
起价:0元 当前价:2元 -
Lot.29
苏联1980年莫斯科奥运会跳高半盎司纯银纪念银币 16.58克
起价:0元 当前价:0元 -
Lot.30
苏联1980年莫斯科奥运会1盎司纯银精制纪念银币 33.53克
起价:0元 当前价:2元 -
Lot.31
苏联1980年莫斯科奥运会1盎司纯银精制纪念银币 33.16克
起价:0元 当前价:2元 -
Lot.32
苏联1980年莫斯科奥运会半盎司纯银精制纪念银币 16.59克
起价:0元 当前价:0元 -
Lot.33
苏联1980年莫斯科奥运会半盎司纯银精制纪念银币 16.39克
起价:0元 当前价:0元 -
Lot.34
苏联1980年莫斯科奥运会半盎司纯银精制纪念银币 16.36克
起价:0元 当前价:0元 -
Lot.35
苏联1980年莫斯科奥运会半盎司纯银精制纪念银币 16.62克
起价:0元 当前价:0元 -
Lot.36
荷兰精制银币2012年 重15.5克 阿姆斯特丹运河世界文化遗产主题
起价:0元 当前价:0元 -
Lot.37
荷兰双盾徽精制银章 25克 铸造精细
起价:0元 当前价:0元 -
Lot.38
荷兰三盾徽精制银章 25克 铸造精细
起价:0元 当前价:0元 -
Lot.39
荷兰上艾瑟尔省精制银章2000年 28.3克 古杜卡特图案复刻
起价:0元 当前价:0元 -
Lot.40
荷兰杜卡特复刻精制银章1989年 28.3克
起价:0元 当前价:0元 -
Lot.41
荷兰泽兰省精制银章2002年 28.3克 带盒证
起价:0元 当前价:0元 -
Lot.42
荷兰杜卡特复刻精制银章1992年 28.3克 带盒证
起价:0元 当前价:0元 -
Lot.43
巴哈马双火烈鸟精制银币1974年 33.3克
起价:0元 当前价:0元 -
Lot.44
朝鲜2朝鲜元精制银币 2000年 7克 预祝德国世界杯纪念
起价:0元 当前价:0元 -
Lot.45
澳大利亚母子组合银币2枚1套2006年 重32.2克 世界杯主题 无盒证
起价:0元 当前价:0元 -
Lot.46
澳大利亚母子组合银币2枚1套2006年 重32.2克 世界杯主题 带盒证 盒严重破损
起价:0元 当前价:0元 -
Lot.47
英国加厚1镑精制银币1989年 蓟草皇冠图案 重19克 加厚版 状态很好 盒证齐全
起价:0元 当前价:0元 -
Lot.48
美国哥伦布发现新大陆500周年精制银币1992年 26.8克 无盒证
起价:0元 当前价:0元 -
Lot.49
纽埃情人节心形镶钻银币2023年 重20克 盒证齐全 盒有小裂
起价:0元 当前价:0元 -
Lot.50
加拿大力量之马炫彩银币2010年 重25.3克 盒证齐全
起价:0元 当前价:0元 -
Lot.51
法国巴黎镀金大铜章1998年 重82.1克直径50.6mm
起价:0元 当前价:0元 -
Lot.52
德国兴登堡5马克银币1936年 重13.9克 底板带转光
起价:0元 当前价:2元 -
Lot.53
德国1马克银币1914年 重5.6克 底板带转光 长翅鹰
起价:0元 当前价:0元
列表

金瓯永固
认证
2年店铺
保证金
进行中
1月21日 星期三 20:07
金瓯小拍第三期 古今币章 银价专场
押 ¥100
共71件
注:本场拍卖收取买家佣金,每件最少5元,费率5%
拍卖须知
- 竞拍前若对拍品有任何疑问可提前咨询,请在充分了解拍品品相及全部相关信息后出价,中拍后非赝品不予退换,谢绝议价;
- 竞拍成功后请于 24 小时内完成付款,无故逾期未付款将按平台规则扣除竞拍押金;
- 所有拍品图片均为实拍原片,因拍摄光源、显示设备差异,可能存在轻微色差,敬请知悉;
- 拍品在付款完成后,将在 5 个工作日内安排快递发出,如需办理保价服务,相关费用由买家承担,可在支付订单前提前联系沟通。
如何购买或参与拍卖?
方式1:微信扫码打开小程序

方式2:扫码下载安装APP